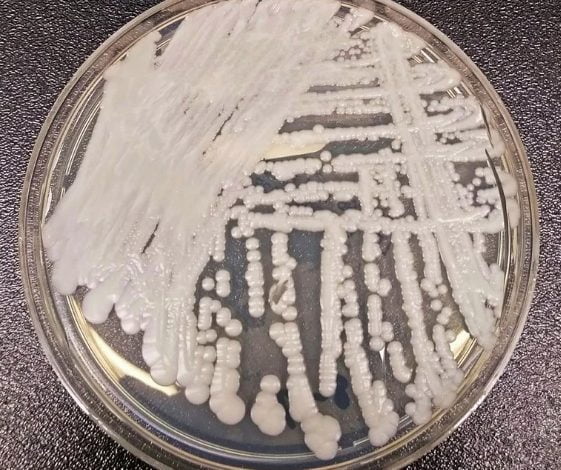
s&uacute;per hongo

Brasil en alerta epidemiológica por el brote de un Súper Hongo
En el 2009 fue cuando encontraron por primera vez el Súper Hongo en el canal auditivo de un paciente en Corea del Sur
🚨 Noticias al instante en WhatsApp
Únete GRATIS a nuestro canal y recibe las alertas más importantes antes que todos.
👉 Seguir canal en WhatsAppBrasil entró en emergencia epidemiológica, tras confirmarse el tercer caso positivo de infección con el hongo Candida auris, más conocido como ‘El súper hongo’.
Este hongo causa infecciones sanguíneas graves y afecta más a las personas que están internadas en hospitales y hogares de personas mayores.
“Aunque por el momento solo hay tres casos confirmados y otro en análisis, se puede considerar que hay un brote de Candida auris en el país”, indicó la Agencia Nacional de Vigilancia Sanitaria (Anvisa).
La Agencia explicó que la “definición epidemiológica” de un brote “abarca no solo una gran cantidad de casos de enfermedades contagiosas o relacionadas con la salud, sino también la aparición de un nuevo microorganismo en la epidemiología de un país o incluso de un servicio de salud, incluso si es solo un caso”.
El tercer paciente infectado se encuentra internado en el hospital público de Recife, del estado de Pernambuco, al nordeste del país.
¿Cuáles son los síntomas del ‘Súper Hongo’?
Este hongo genera fiebre y escalofríos. Si al usar antibióticos, la persona no mejora, se sospecha de una infección bacteriana.
🚨 Últimas noticias en tiempo real
Únete GRATIS a nuestro canal y recibe alertas antes que todos.
👉 Suscribirme en TelegramEn el 2009 fue cuando encontraron por primera vez el Súper Hongo en el canal auditivo de un paciente en Corea del Sur. A partir de esa fecha, la bacteria empezó a expandirse en otros países como Estados Unidos, Inglaterra, Venezuela, Colombia, Israel, Pakistán, Kenia, Kuwait, España y Brasil.
TAMBIÉN PUEDES LEER: Tinnitus: nuevo síntoma de la variante ómicron





